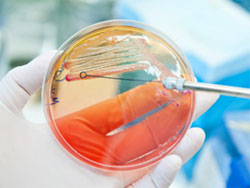

Bebelușii s-au îmbolnăvit de la vaccinuri. Corpul de control al Guvernului a sesizat Parchetul în cazul copiilor cu SHU
 Corpul de control al Guvernului a efectuat mai multe verificări în cazul copiilor cu sindrom hemolitic uremic (SHU) transferaţi de la Spitalul de Pediatrie Piteşti la Spitalul Clinic de Urgenţă pentru Copii Maria Sklodowska Curie. În urma controalelor efectuate, a fost sesizat Parchetul de pe lângă Înalta Curte de Casaţie şi Justiţie. Astfel, potrivit unei note de informare a Corpului de control, s-au constatat numeroase nereguli.
Corpul de control al Guvernului a efectuat mai multe verificări în cazul copiilor cu sindrom hemolitic uremic (SHU) transferaţi de la Spitalul de Pediatrie Piteşti la Spitalul Clinic de Urgenţă pentru Copii Maria Sklodowska Curie. În urma controalelor efectuate, a fost sesizat Parchetul de pe lângă Înalta Curte de Casaţie şi Justiţie. Astfel, potrivit unei note de informare a Corpului de control, s-au constatat numeroase nereguli.
În judeţul Argeş au fost internaţi 16 copii, dintre care 13 cu patologie digestivă, cărora le-au fost stabilite mai multe diagnostice. Corpul de control a constatat că majoritatea celor internaţi aveau un sistem imunitar slăbit din cauza altor afecţiuni precedente internării. Bebelușilor le fuseseră administrat anterior vaccinul hexavalent şi alte vaccinuri.
O altă problemă semnalată este că dezinfecţia în ambele spitale verificate a fost făcută cu produse Hexi Pharma.
Deși Raportul Corpului de Control îi indică direct responsabili de aducerea vaccinului neautorizat Hexaxim, cei de la Ministerul Sănătății continuă să mintă și să manipuleze cu „îmbolnăvirile cu E.coli”. E timpul ca cei de acolo să răspundă în fața Justiției!
Vremea comunicatelor a trecut. Cei din Ministerul Sănătății care sunt responsabili vor trebui de acum să dea „comunicate” Parchetului de pe lângă Înalta Curte de Casaţie şi Justiţie.
Corpul de control al premierului a constatat, în urma verificărilor efectuate în legătură cu situația copiilor transferați cu afecțiuni grave la Spitalul Marie Curie că, în perioada 17 octombrie 2013 – 3 februarie 2016, în baza contractelor încheiate cu Ministerul Sănătății, societatea Polisano SRL a livrat către direcțiile de sănătate publică din țară 940.995 doze de vaccin hexavalent, din care 11.800 doze vaccin Hexacima în ambalaj slovac, 20.042 doze vaccin Hexacima în ambalaj bulgăresc și 107.300 doze vaccin Hexaxim, destinat pieței din Kazahstan.
 Corpul de control remarcă faptul că, deși Agenția Națională a Medicamentului și a Dispozitivelor Medicale a comunicat Ministerului Sănătății faptul că vaccinul Hexaxim, destinat pieței din Kazahstan, este un „medicament neautorizat de punere pe piață”, care deține numai o opinie științifică pozitivă din partea Agenției Europene pentru Medicamente, firma Polisano SRL a fost autorizată de către Ministerul Sănătății – adică exact de către cei care dau comunicate – să distribuie 107.300 doze x 0,5 ml din vaccinul Hexaxim, cu mai multe obligații:
Corpul de control remarcă faptul că, deși Agenția Națională a Medicamentului și a Dispozitivelor Medicale a comunicat Ministerului Sănătății faptul că vaccinul Hexaxim, destinat pieței din Kazahstan, este un „medicament neautorizat de punere pe piață”, care deține numai o opinie științifică pozitivă din partea Agenției Europene pentru Medicamente, firma Polisano SRL a fost autorizată de către Ministerul Sănătății – adică exact de către cei care dau comunicate – să distribuie 107.300 doze x 0,5 ml din vaccinul Hexaxim, cu mai multe obligații:
– să se asigure că seria distribuită în România va avea buletine de analiză conforme şi certificat de eliberare în conformitate cu legislaţia europeană;
– să urmărească eventualele reacţii adverse apărute după administrare;
– să informeze Agenţia Naţională a Medicamentului în legătură cu calitatea produsului.
Ca urmare a celor depistate, Corpul de control s-a adresat Parchetului de pe lângă Înalta Curte de Casaţie şi Justiţie pentru a efectua verificări privind situaţia reală a stocurilor de vaccinuri şi calitatea vaccinurilor administrate.
Mai mult, în urma controalelor s-a stabilit că vaccinul nu a fost ţinut în condiţii corespunzătoare, ceea ce ar fi influenţat calitatea acestuia.
În pofida acestui fapt, Ministerul Sănătății se trezește să dea un comunicat în care cu tupeu neagă faptele, reluând minciunile cu E. coli şi cu îmbolnăvirea bebelușilor „de la lactate”.
Demontăm în continuare minciunile și manipulările propagate din nou de Ministerul sănătății în comunicatul său:
1. Niciunul dintre cei trei bebeluși morți nu a murit din cauza E.coli. Acestea nu sunt concluziile noastre ci concluziile IML și ale Spitalelor unde cei mici au fost internați
Întrebare pentru Ministerul Sănătății : De ce minte ministerul, în continuare, că acești bebeluși au murit de la E.coli dacă fișele medicale ale deceselor lor indică clar că bebelușii NU au murit din cauza bacteriei E.coli?
A doua întrebare pentru Ministerul Sănătății: Dacă bebelușii nu au murit din cauza E.coli, din ce cauză s-a declanșat SHU-ul la bebelușii morți?
Primul bebeluș mort nu a avut E.coli care produce boli
 „Unul dintre copii a decedat în 4 februarie 2016, și a fost confirmat cu E.coli nepatogen”, comunica Ministerul Sănătății, citat de Agerpres.
„Unul dintre copii a decedat în 4 februarie 2016, și a fost confirmat cu E.coli nepatogen”, comunica Ministerul Sănătății, citat de Agerpres.
Pentru a fi cât se poate de clar, „traducem” ce anume se spune în afirmația de mai sus:
Patogen = adj. Care se referă la boală; care provoacă boli, infecții; purtător de boli. – Din fr. pathogène (Dex ʼ98)
Nepatogen = adj. (prin negarea lui patogen) care NU provoacă boli, infecții.
Așadar, „Unul dintre copii a decedat în 4 februarie 2016, și a fost confirmat cu E.coli care nu produce boli.”
Al doilea bebeluș mort – nu a avut niciun fel de E.coli
Al doilea deces a survenit în dimineața zilei de 15 februarie 2016.
Spre deosebire de primul caz, medicii de la Spitalul Cantacuzino au comunicat că nu au găsit nici urmă de E.coli la al doilea bebeluș mort. Cu toate acestea, ei nu au comunicat nimic legat de cauza decesului.
A fost găsit doar Rotavirus care nu poate fi pus în legătură cu SHU. Specificarea repetată a prezenței Rotavirusurilor a fost o altă manipulare.
Potrivit Ministerului Sănătății, coproculturile testate la Cantacuzino de la ultimele trei cazuri internate la Spitalul Marie Curie în datele de 9 și 10 februarie 2016 au fost negative pentru E.coli, între acestea aflându-se și cazul celui de-al doilea copil decedat.
„Ancheta epidemiologică va continua pentru a verifica posibilitatea existenței altor surse de alimente de origine animală (produse lactate nepasteurizate, carne de vită) care ar putea fi sursa îmbolnăvirii”, se menționează în același comunicat al Ministerului.
Aici se strecoară o altă minciună. Copii de 5 luni cum este cel al dnei Maria Dulgheru au mâncat doar lapte praf.
Nici la al treilea bebeluș mort NU s-a găsit E.coli și niciun alt microb
 De fapt în cazul lui nu mai aflăm nimic decât că „nu se cunoaște cauza”.
De fapt în cazul lui nu mai aflăm nimic decât că „nu se cunoaște cauza”.
Copilul a decedat din cauza complicaţiilor bolii şi „nu se cunoaşte cauza ca nume de microb” a spus, pentru Mediafax, dr. Mihaela Bălgrădean, şefa Secţiei Nefrologie de la Spitalul Marie Curie.
Această afirmație stârnește o mare nedumerire. Dacă „nu se cunoaște cauza ca nume de microb”, de unde știe dna Bălgrădean că bebelușul a murit din cauza unui microb? Unde este procuratura să facă o expertiză medico-legală asupra cauzelor morții acestui bebeluș?
2. La niciunul, dar absolut la niciunul dintre copiii îmbolnăviți de SHU, nu s-a putut identifica prezența unei bacterii E.coli patogene în materiile fecale ale acestora.
Manipularea Ministerului cum că E.coli „a dispărut rapid” este penibilă. Cum de s-au găsit la unii bebeluși E.coli nepatogene (care nu îmbolnăvesc)? Acele bacterii de ce ce n-au dispărut rapid?
Ce „a dispărut rapid” mai degrabă nici n-a fost, ca să punctăm direct manipularea făcută.
3. La niciunul, dar absolut la niciunul dintre copiii îmbolnăviți de SHU, nu a apărut în sângele lor verotoxine corespunzătoare unor bacterii ucigașe.
Nu credeți? Cerem Ministerul Sănătății să publice toate analizele medicale ale tuturor bebelușilor îmbolnăviți, care să ne arate clar prezența verotoxinelor ucigașe provenite de la E.coli patogene la acești bebeluși.
4. Ministerul Sănătății a justificat prezența bacteriei E. Coli tip O26 nu pe baza identificării bacteriei sau a verotoxinei ei, ci pe baza unor anticorpi din organism care luptau împotriva acestei verotoxine care ar fi fost detectați la un laborator în Italia. Ministerul Sănătății NU a dat însă niciodată publicității aceste analize. Poate că ar fi timpul să o facă să vedem și noi acest raport.
Mai mult, prezența unor anticorpi NU este un element hotărâtor. Elementele directe sunt: prezența bacteriei în fecale și prezența verotoxinei ei ucigașe în sânge.
 Din ce a spus Alexandru Rafila, atunci când după o lună de bâlbâieli a anunțat că a găsit cauza îmbolnăvirilor, prezența acestor anticorpi ar fi fost semnalată la doar șase bebeluși dintre care doar trei din Argeș. Trei din 19 îmbolnăviți grav în Argeş ar fi avut acești anticorpi. Pe baza acestor cifre a declarat Rafila că ar fi găsit cauza deceselor!
Din ce a spus Alexandru Rafila, atunci când după o lună de bâlbâieli a anunțat că a găsit cauza îmbolnăvirilor, prezența acestor anticorpi ar fi fost semnalată la doar șase bebeluși dintre care doar trei din Argeș. Trei din 19 îmbolnăviți grav în Argeş ar fi avut acești anticorpi. Pe baza acestor cifre a declarat Rafila că ar fi găsit cauza deceselor!
După ce a apărut această declarație, orice bebeluș care se îmbolnăvea era declarat ca având O26 ba de la „supiță”, ba de la „sarmale”, ba de la „puiul din curte”.
Timp de 25 de zile nu s-a găsit bacteria ucigașă în nicio coprocultură deși sunt oficial peste 30 de îmbolnăviri (probabil sunt mult mai multe). Bacteria nu a fost găsită nici până în ziua de azi. Timp de aproape o lună nu s-a găsit în sângele niciunui copil toxina asociată cu vreuna dintre bacteriile ucigașe.
Brusc după ce apar alte cinci îmbolnăviri noi, Rafila și Achimaş ne spun că nu s-a găsit bacteria ucigașă, că nu s-a găsit toxina ei, dar s-au descoperit la analizele făcute în Italia anticorpi la șase din 13 probe trimise.
5. De ce continuă Ministerul să mintă cu epidemia de E.coli știind că de la E.coli s-ar fi îmbolnăvit și copiii și adulții?
Afirmația Ministerul Sănătății cum că „Cea mai probabilă sursă de îmbolnăvire o reprezintă unul sau mai multe produse lactate” este de-a dreptul mincinoasă. Iar cinismul celor de la Minister care au redactat acest comunicat este maxim, știind că doamna Maria Dulgheru a declarat pentru ziarul Adevărul că bebelușul ei, care s-a îmbolnăvit grav de SHU, era hrănit doar cu lapte praf. Cum s-ar fi putut îmbolnăvi un bebeluș de la ceva ce nu i-a fost administrat?
Observați că la patru luni după ce au murit bebelușii, ministerul ne vorbește cu „cel mai probabil”, „se pare că”, „se poate că” etc…
Nu e nici măcar „probabil” – e chiar improbabil.
Cum laptele praf, în cazul nostru singurul aliment care ar fi putut fi administrat doar bebelușilor, nu a fost găsit infestat, o astfel de epidemie de E.coli „de la lactate”, care să fi îmbolnăvit doar bebeluși, nu există.
Ministerul Sănătății știe, ca toți ceilalți, că la o epidemie de E.coli de la unul sau mai multe produse lactate se îmbolnăvesc în egală măsură și copiii și adulții. Dacă E.coli ucigașă ar fi provenit din lapte, brânză sau carne etc, ar fi fost îmbolnăviri și în rândul adulților și al copiilor. Să ne arate Ministerul Sănătății, că tot vorbește doar de „probabil”, o singură epidemie mondială de E.coli care să fi pornit de la alimente (lactate) și în care să fi fost afectați doar bebelușii. Nu există niciuna. Deci probabilitatea e zero.
Ministerul Sănătății știe, ca toți ceilalți, că la o epidemie de E.coli de la unul sau mai multe produse lactate se îmbolnăvesc în egală măsură și copiii și adulții. Dacă E.coli ucigașă ar fi provenit din lapte, brânză sau carne etc, ar fi fost îmbolnăviri și în rândul adulților și al copiilor. Să ne arate Ministerul Sănătății, că tot vorbește doar de „probabil”, o singură epidemie mondială de E.coli care să fi pornit de la alimente (lactate) și în care să fi fost afectați doar bebelușii. Nu există niciuna. Deci probabilitatea e zero.
Epidemie doar la bebeluși înseamnă că ceva a fost administrat doar lor. Ce a fost administrat doar bebelușilor în cazul nostru?
6. În loc să identifice cauzele îmbolnăvirilor, Ministerul Sănătății vorbește cu „în general” și cu „din punct de vedere statistic”.
Ministerul Sănătății este același care în luna martie a dat un comunicat rușinos, spunând că nu există studii științifice care să arate legătura dintre vaccinuri și declanșarea de SHU atipic. După ce pe diferite site-uri s-au publicat astfel de studii medicale, Ministerul Sănătății revine și recunoaște că există legături dintre vaccinuri și SHU, dar ne spune că sunt cazuri rare…
Cu asemenea mușamalizări, desigur că „sunt cazuri rare”, din moment ce nu sunt investigate serios.
Niciunde în lume nu se administrează bebelușilor la scară națională vaccinuri neautorizate pentru a fi puse pe piață.
7. Ministerul Sănătății este direct responsabil de aducerea unui vaccin neautorizat pentru punerea pe piață, vaccin care a fost aplicat bebelușilor din România.
Cei din Ministerul Sănătății care au adus Hexaximul și au administrat bebelușilor din țară un vaccin neautorizat pe piață, vor trebui să răspundă în fața Justiției pentru acest lucru, așa cum cere și Raportul Corpului de Control al Primului Ministru.
Ei vor trebui să răspundă și pentru toate manipulările făcute.
COMUNICATUL MINISTERULUI SĂNĂTĂȚII
Bucureşti, 25-05-2016
Comunicat de presă
Sindromul Hemolitic-Uremic al copiilor din Argeș nu are nicio legătură medicală cu vaccinarea
 Având în vedere informațiile vehiculate în spațiul public despre o așa-zisă legătură între afecțiunile digestive grave ale copiilor din Argeș și vaccinuri, Ministerul Sănătății insistă asupra următoarelor clarificări:
Având în vedere informațiile vehiculate în spațiul public despre o așa-zisă legătură între afecțiunile digestive grave ale copiilor din Argeș și vaccinuri, Ministerul Sănătății insistă asupra următoarelor clarificări:
La începutul acestui an, au fost înregistrate în România, cu precădere în județul Argeș, 24 de cazuri de afecțiuni digestive grave la copii. Dintre aceștia, 19 copii au dezvoltat Sindrom Hemolitic-Uremic.
La 11 cazuri a fost confirmată prezența aceleiași tulpini de bacterie E.coli enterohemoragică de tip O26. Bacteria E.coli enterohemoragică este, din punct de vedere statistic, cea mai frecventă cauză a Sindromului Hemolitic-Uremic.
Investigațiile epidemiologice derulate până în prezent arată că România s-a confruntat cu un focar epidemic determinat de infecții cu E.coli enterohemoragic O26. Cea mai probabilă sursă de îmbolnăvire o reprezintă unul sau mai multe produse lactate.
La unele probe prelevate din produsele lactate s-a demonstrat prezența bacteriei E.coli enterohemoragice sau a toxinei care provoacă Sindromul Hemolitic-Uremic. Este vorba despre produsele lactate indicate de părinții copiilor. Produsele au fost consumate fie de copii, fie de părinții lor.
În literatura medicală de specialitate, cazurile de Sindrom Hemolitic-Uremic presupuse a fi corelate cu o vaccinare sunt extrem de rare. În ultimii 15 ani, numărul acestora nu depășește 10 la nivel mondial.
Chiar și în aceste cazuri presupuse, manifestările au apărut într-un termen maxim de 14 zile de la vaccinare, nicidecum în termene de mai multe luni de la ultima vaccinare cum este cazul copiilor din Argeș. În plus, prezența bacteriei E.coli enterohemoragice dovedită la copiii din Argeș presupune ingerarea de produse neconforme și prezența în tubul digestiv.
În concluzie, Ministerul Sănătății afirmă că nu poate fi făcută o legătură între îmbolnăvirea copiilor din Argeș cu E.coli enterohemoragic și vaccinări.
Este regretabil că asocierea în spațiul public a unor teme independente dintr-un raport de control riscă să pună în pericol campanii de vaccinare necesare pentru evitarea reapariției unor fenomene epidemice în România.
Citiți și:
Dovezi ştiinţifice: Bacteria E. coli nu poate fi cauza decesului copiilor şi nici a sindromului hemolitic uremic
11 ingrediente toxice care provoacă boli și care se găsesc în vaccinuri
Poliţia vaccinurilor. Proiect de lege totalitar care instituie vaccinarea forţată şi condiţionarea înscrierii copiilor la grădiniţă şi şcoală (I)
yogaesoteric
10 iulie 2016
